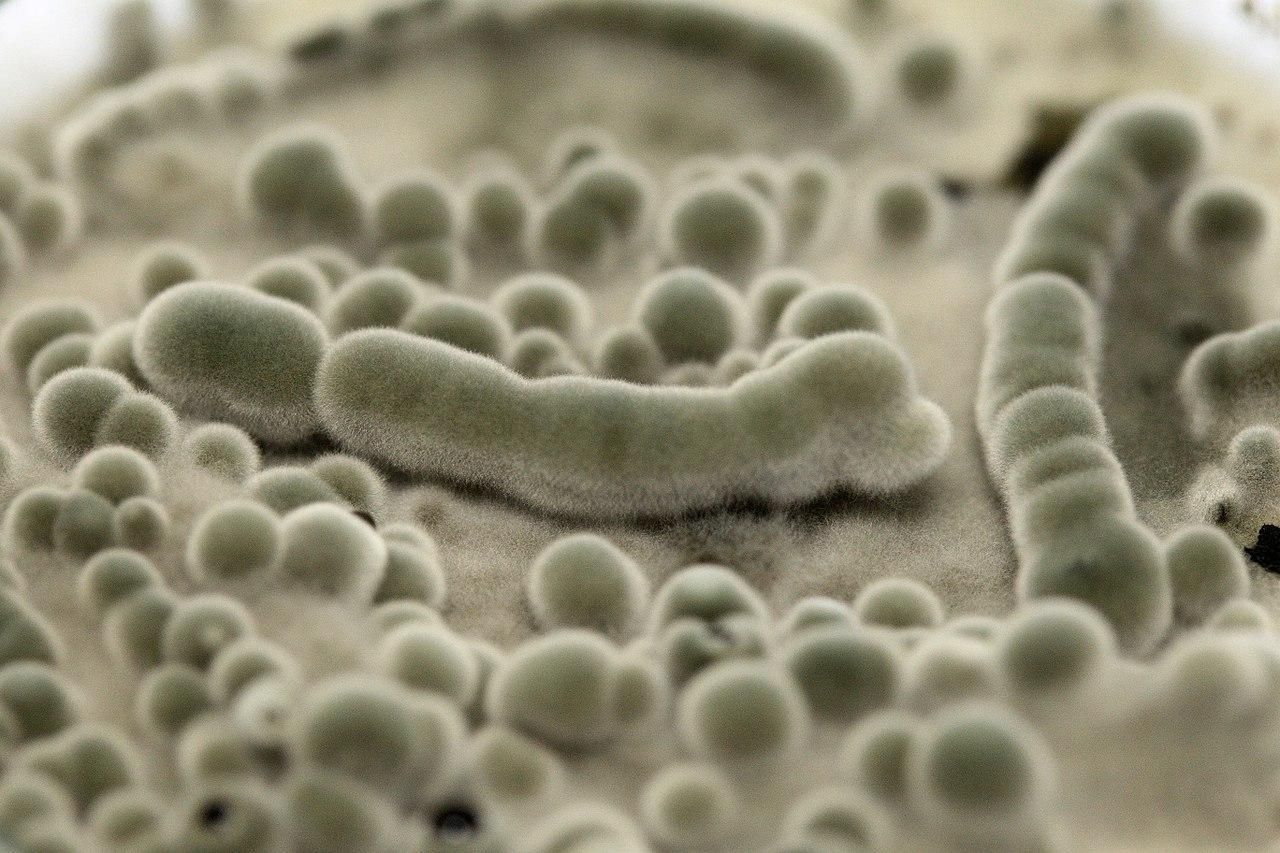
Захистити астронавтів від космічної радіації допоможе грибок: перспективне відкриття - Новини технологій - Техно Захистити астронавтів від космічної радіації допоможе грибок: перспективне відкриття - Новини технологій - Техно

На Землі від космічної радіації та іншого випромінювання нас захищає магнітосфера. Астронавти на МКС вже отримують більшу кількість радіації, але все ще знаходяться досить близько до планети, щоб протягом року безпечно залишатися на станції. Однак у випадку далеких подорожей доводиться шукати альтернативу.
Цікаво У Швеції створили рослини, здатні накопичувати електрику в коренях та передавати її
Особливий грибок
На Землі існує особливий грибок Cladosporium sphaerospermum з роду Кладоспорій. Росте він саме в умовах підвищеної радіації й не тільки затримує випромінювання, але і фактично харчується ним за допомогою радіосинтезу: черпає з нього енергію, як роблять це рослини з сонячного світла.
Ці любителі радіації володіють феноменальною живучістю і ростуть в таких непривітних середовищах, як, наприклад, Чорнобильська АЕС. У космічному вакуумі вони почуваються не менш добре.
Cladosporium sphaerospermum / Фото Wikimedia Commons, Medmyco
- У 2019 році команда біологів відправила посів Cladosporium sphaerospermum на МКС.
- Вчені спостерігали за їх ростом протягом місяця, а потім зняли виміри радіації поблизу грибка в порівнянні з контрольною ділянкою, де його не було.
- Під грибковим прошарком в 1,7 міліметра рівень випромінювання виявився на 2,17 відсотка нижче контрольної зони.
- Крім того, у космосі грибок розвивався приблизно у 1,2 раза активніше, ніж на Землі.
Недоліки рішення
Зараз ще дуже рано говорити про практичне застосування грибка в далеких космічних мандрах. За оцінками дослідників, для зниження рівня радіації на Марсі до земного, потрібну для обживання площу необхідно покрити шаром Cladosporium sphaerospermum товщиною 2,3 метра. Це вкрай багато і непрактично, однак дослідження продовжуються. Можливо, вчені сподіваються покращити властивості поглинання радіації.